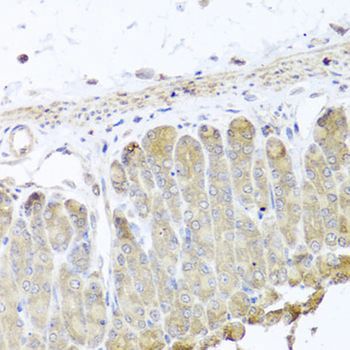

Amerigo Scientific
Anti-IRS2 antibody | Amerigo Scientific
This gene encodes the insulin receptor substrate 2, a cytoplasmic signaling molecule that mediates effects of insulin, insulin-like growth factor 1, and other cytokines by acting as a molecular adaptor between diverse receptor tyrosine kinases and downstream effectors. The product of this gene is phosphorylated by the insulin receptor tyrosine kinase upon receptor stimulation, as well as by an interleukin 4 receptor-associated kinase in response to IL4 treatment.
Amerigo Scientific is a distribution company focused on providing critical products and services to the biomedical and life science research communities. Although a new company, Amerigo Scientific's founder has had more than 20 years of rich experience in the biomedical and biochemical fields, and has established close contacts with key personnel in...
READ MORE
More Scientific Products from Amerigo Scientific
Opens in a new window
Opens an external site
Opens an external site in a new window

























































